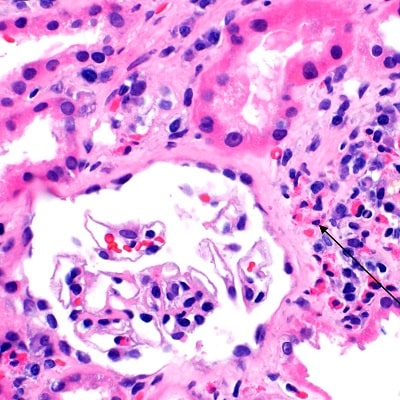

مشخصات رنگ هماتوکسیلین
نام انگلیسی: Hematoxylin cryst
Papanicolaou’s solution 1a Harris’ hematoxylin solution
نام رایج: هماتوکسیلین – رنگ هماتوکسیلین – محلول هماتوکسیلین
فرمول شیمیایی: C₁₆H₁₄O₆
Cas number: 517-28-2
Merck Catologue Number:104302 – 109253